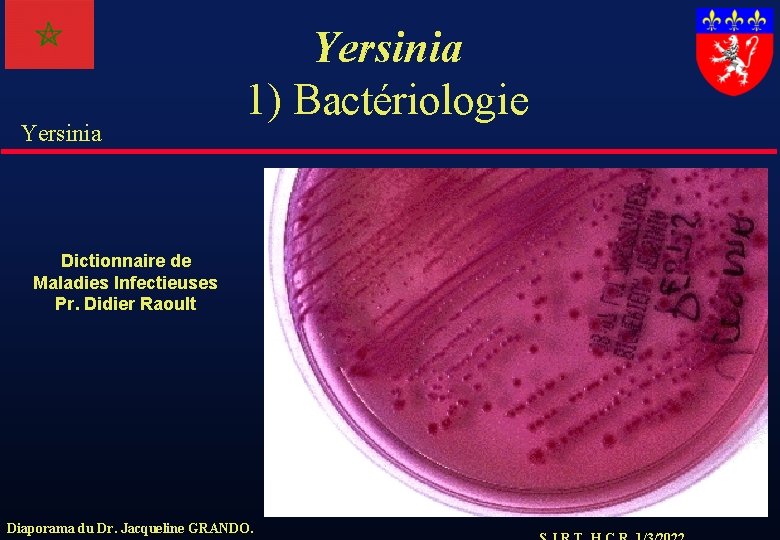
Yersinia 1) Bactériologie Dictionnaire de Maladies Infectieuses Pr. Didier Raoult Diaporama du Dr. Jacqueline

Yersinia Cours de Bactriologie Facult de Mdecine de

Yersinia Cours de Bactériologie Faculté de Médecine de Fès Dr. Sylvestre Tigaud Laboratoire de Bactériologie Centre de Biologie Nord Hôpital de la Croix-Rousse CHU de LYON Diaporama du Dr. Jacqueline GRANDO.

Yersinia Dr. Sylvestre Tigaud sylvestre. tigaud@chu-lyon. fr Tel : +33 4 72 07 18 44 Fax : +33 4 72 07 18 42 Hôpital de la Croix-Rousse Diaporama du Dr. Jacqueline GRANDO.

Yersinia 1) Bactériologie • Entérobactéries avec une croissance difficile, donnant des colonies minuscules. • Les corps bactériens sont également petits (Anciennes « Parvobactéries » ) • Immobiles à 37°C, mobiles à 24°C • 3 bactéries d ’intérêt médical : – Yersinia pestis (Agent de la Peste !!!) – Yersinia enterocolitica – Yersinia pseudotuberculosis Diaporama du Dr. Jacqueline GRANDO.

Yersinia 1) Bactériologie Dictionnaire de Maladies Infectieuses Pr. Didier Raoult Diaporama du Dr. Jacqueline GRANDO.
Yersinia 1) Bactériologie Dictionnaire de Maladies Infectieuses Pr. Didier Raoult Diaporama du Dr. Jacqueline GRANDO.

Yersinia 2) Yersinia pestis-Ecologie • Bactéries pathogènes des rongeurs sauvages (rat) et qui peut survivre longtemps dans la nature • les puces sont les vecteurs habituelles de la maladie • Quelques zones d’épidémies dans le monde : • Europe : Caucase, Arabie • Inde et Sud-est asiatique • Afrique Centrale et Madagascar • Amérique Diaporama du Dr. Jacqueline GRANDO.

Yersinia 2) Yersinia pestis-Ecologie Dictionnaire de Maladies Infectieuses Pr. Didier Raoult Diaporama du Dr. Jacqueline GRANDO.

Yersinia 2) Yersinia pestis-Pouvoir pathogène • Grande virulence (production d’une glycoprotéine d’enveloppe : capsule protégeant de la phagocytose) : agent de la Peste. • Forme bubonique – Gonflement inflammatoire du ganglion 3 à 5 jours après la piqûre de la puce infectante – septicémie, mort dans 70% des cas Diaporama du Dr. Jacqueline GRANDO.

Yersinia 2) Yersinia pestis-Pouvoir pathogène • Forme pulmonaire : inhalation de particules infectieuses – incubation rapide, pseudo-grippale – hémorragies pulmonaires très contagieuses – rapidement mortelle • C ’est ce que l’on appelait au Moyen-Age la « Peste Noire » Diaporama du Dr. Jacqueline GRANDO.

Yersinia 2) Yersinia pestis-Diagnostic et Yersinia traitement • Diagnostic biologique : direct, utilisant la culture ou la PCR • à partir pus, adénopathies, hémocultures, expectorations • Traitement • Tétracycline, Sulfamides, Chloramphénicol, Aminosides, Fluoroquinolones Diaporama du Dr. Jacqueline GRANDO.

Yersinia 3) Yersinia enterocolitica. Ecologie-Bactériologie • Entérobactérie vivant dans le tube digestif des animaux largement répandue dans l'environnement • Peut se multiplier à 4°C (psychrophiles) • Culture facile et identification biochimique • Peut sécréter une entérotoxine • Dans le tube digestif, elles se multiplient dans les plaques de Peyer. Diaporama du Dr. Jacqueline GRANDO.

Yersinia • • Yersinia 3) Yersinia enterocolitica. Pouvoir pathogène : Infections digestives (origine alimentaire) Diarrhées, entérocolites Adénites mésentériques !!! (Appendicite ? ) Arthrite réactionnelle (un processus immunologique) Diaporama du Dr. Jacqueline GRANDO.

Yersinia 3) Yersinia pseudotuberculosis. Yersinia Ecologie-Bactériologie • Entérobactérie vivant dans le tube digestif des animaux, largement répandue dans l'environnement (oiseaux, rongeurs, carnivores, ) • Contamination digestive • Adénite mésentérique souvent tableau pseudoappendiculaire Diaporama du Dr. Jacqueline GRANDO.
- Slides: 13